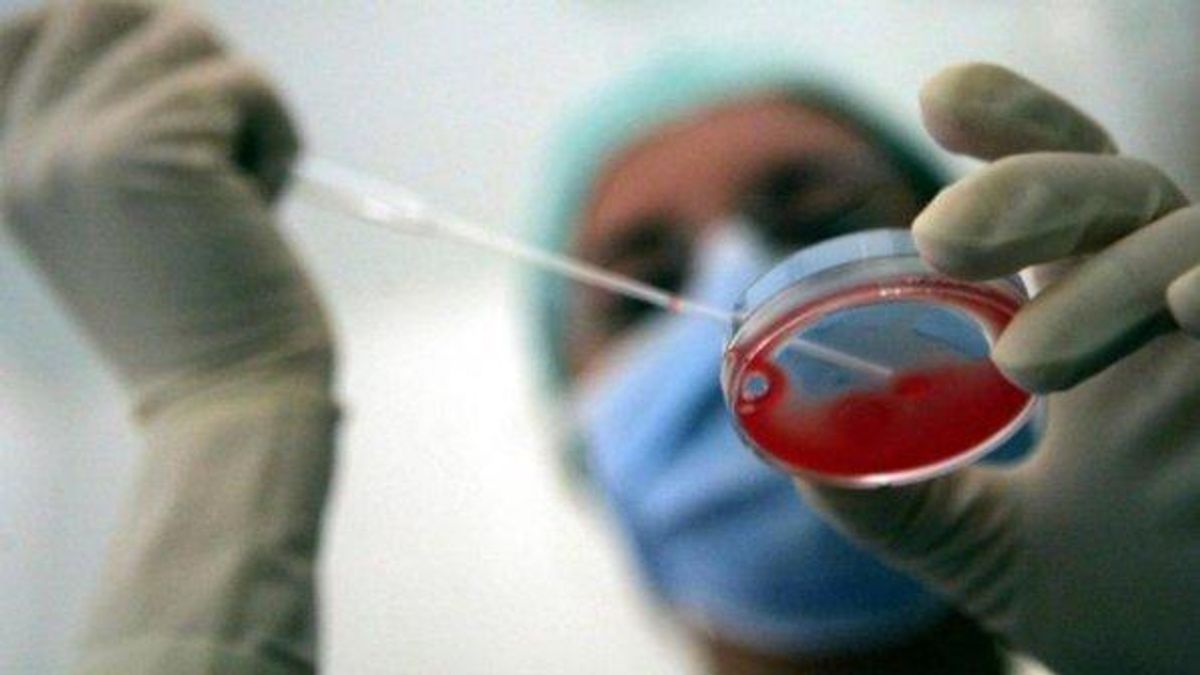
© ansa

Tumore al polmone, dall'immunoterapia arriva una nuova speranza per i malati gravi
Un nuovo farmaco ha dimostrato di poter aumentare le chance di sopravvivenza nel 57% dei casi a tre anni dalla diagnosi
© ansa
Dall'immunoterapia arriva una nuova speranza per i pazienti con tumore al polmone in stadio avanzato. Un nuovo farmaco, il durvalumab, ha infatti dimostrato per la prima volta di aumentare significativamente la sopravvivenza nei malati gravi: il 57% di essi, sottoposti a un approccio innovativo che punta a risvegliare il sistema immunitario per combattere le cellule cancerose, è infatti vivo dopo tre anni. La buona notizia è stata diffusa dalla Società americana di oncologia clinica.
Gli oncologi parlano di "grande risultato" per una categoria di pazienti con poche armi a disposizione e per i quali da due decenni non si registrava alcuna novità sul fronte delle cure.
La nuova immunoterapia si è dunque dimostrata efficace contro il tumore del polmone non a piccole cellule, la tipologia più diffusa di carcinoma polmonare, in stadio avanzato e non operabile, che in Italia registra oltre 12mila nuovi casi l'anno su un totale di 35mila casi. E' viva dopo tre anni oltre la metà dei pazienti (57%) rispetto al 43,5% trattato con placebo.
Lo studio è stato condotto in 235 centri in 26 Paesi e ha coinvolto 713 pazienti. Si tratta del primo trattamento immunoterapico che abbia fatto registrare un dato positivo di sopravvivenza a tre anni per questa categoria di pazienti. Inoltre gli ultimi risultati hanno mostrato un'efficacia costante e duratura, mantenendo una riduzione del 31% del rischio di morte per i malati gravi.
Secondo gli esperti, i risultati della ricerca "sono estremamente incoraggianti per pazienti che da 15 anni non avevano a disposizione nessuna nuova arma terapeutica e confermano durvalumab quale prima immunoterapia a dimostrare un beneficio significativo di sopravvivenza globale". Prima della disponibilità del farmaco, i tassi di sopravvivenza a cinque anni per questi pazienti erano limitati al 15-30%.
Gli scienziati hanno però evidenziato anche effetti avversi. Il 30,5% dei pazienti ha manifestato un evento avverso di grado 3 o 4 contro il 26,1% con placebo e il 15,4% ha dovuto interrompere il trattamento rispetto al 9,8% con placebo. I nuovi dati rappresentano a ogni modo un passo avanti significativo nell'utilizzo dell'immunoterapia, la cui efficacia è stata già dimostrata per vari tipi di tumore, come "quarta arma" dell'oncologia dopo la chirurgia, la chemioterapia e la radioterapia.
Ma la sfida è ancora da vincere, perché ad oggi circa la metà dei pazienti oncologici ancora non risponde a tale approccio. Nel 2015 erano circa 200mila i malati in fase avanzata di tumore al polmone nei Paesi più industrializzati (Cina, Francia, Germania, Italia, Giappone, Spagna, Regno Unito, Stati Uniti).



